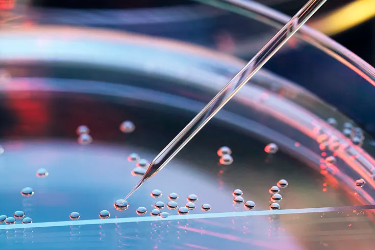
image.png

腫瘤可以用干細(xì)胞療法嗎?與傳統(tǒng)治療哪個(gè)更好?
2024-10-28 15:24:53 來(lái)源: 小編 咨詢(xún)醫(yī)生
干細(xì)胞療法作為一種前沿的生物治療方法,近年來(lái)在腫瘤治療領(lǐng)域引起了廣泛關(guān)注。那么,腫瘤可以用干細(xì)胞療法嗎?它與傳統(tǒng)的腫瘤治療方法相比,哪個(gè)效果更好呢?本文將從專(zhuān)業(yè)角度對(duì)這兩個(gè)問(wèn)題進(jìn)行探討。
一、腫瘤可以用干細(xì)胞療法嗎?
干細(xì)胞療法是一種利用干細(xì)胞修復(fù)或替代受損細(xì)胞、組織的方法。在腫瘤治療中,干細(xì)胞療法主要通過(guò)以下兩種途徑實(shí)現(xiàn):
1.替代受損的正常細(xì)胞:干細(xì)胞具有自我更新和分化能力,可以分化為各種類(lèi)型的細(xì)胞。通過(guò)將干細(xì)胞定向分化為正常細(xì)胞,替代受損的細(xì)胞,從而達(dá)到治療腫瘤的目的。
2.改造腫瘤干細(xì)胞:腫瘤干細(xì)胞是腫瘤生長(zhǎng)、轉(zhuǎn)移的關(guān)鍵因素。通過(guò)基因工程技術(shù)改造腫瘤干細(xì)胞,使其失去惡性生長(zhǎng)的能力,進(jìn)而抑制腫瘤的發(fā)展。
目前,干細(xì)胞療法在部分腫瘤治療中已取得一定成果,如血液系統(tǒng)腫瘤、神經(jīng)母細(xì)胞瘤等。然而,對(duì)于其他類(lèi)型的腫瘤,干細(xì)胞療法的應(yīng)用尚處于研究階段。
二、干細(xì)胞療法與傳統(tǒng)治療哪個(gè)更好?
傳統(tǒng)腫瘤治療方法主要包括手術(shù)、化療和放療。下面我們將從以下幾個(gè)方面對(duì)比干細(xì)胞療法與傳統(tǒng)治療方法:
1.療效:傳統(tǒng)治療對(duì)某些類(lèi)型的腫瘤療效顯著,如早期發(fā)現(xiàn)的乳腺癌、肺癌等。然而,對(duì)于晚期腫瘤或某些難治性腫瘤,傳統(tǒng)治療的療效并不理想。相比之下,干細(xì)胞療法在治療血液系統(tǒng)腫瘤等方面具有較好的療效。
2.副作用:傳統(tǒng)治療往往伴隨著較大的副作用,如惡心、嘔吐、脫發(fā)、免疫力下降等。干細(xì)胞療法副作用相對(duì)較小,對(duì)患者的正常生活影響較小。
3.治療過(guò)程:傳統(tǒng)治療通常需要較長(zhǎng)時(shí)間,且治療過(guò)程中患者需要承受較大的痛苦。干細(xì)胞療法治療過(guò)程相對(duì)較短,痛苦較小。
4.安全性:傳統(tǒng)治療在治療過(guò)程中可能對(duì)正常細(xì)胞造成損傷,引發(fā)并發(fā)癥。干細(xì)胞療法在定向分化為正常細(xì)胞的過(guò)程中,安全性較高。
綜上所述,干細(xì)胞療法在治療某些類(lèi)型的腫瘤方面具有一定的優(yōu)勢(shì),但與傳統(tǒng)治療相比,尚存在一定差距。目前,干細(xì)胞療法仍需進(jìn)一步研究,以便在臨床上廣泛應(yīng)用。
總之,腫瘤可以用干細(xì)胞療法治療,但與傳統(tǒng)治療相比,各有優(yōu)缺點(diǎn)。在選擇治療方法時(shí),患者應(yīng)在專(zhuān)業(yè)醫(yī)生的指導(dǎo)下,結(jié)合自身病情,選擇最適合自己的治療方案。隨著科學(xué)研究的不斷深入,相信未來(lái)干細(xì)胞療法將在腫瘤治療領(lǐng)域發(fā)揮更大的作用。
-
上一頁(yè): 干細(xì)胞療法如何通過(guò)輸液實(shí)現(xiàn)其作用和功效?如何評(píng)估其效果?
-
下一頁(yè): 干細(xì)胞治療睪丸疾病效果怎么樣?
- 2024-10-21海南博鰲國(guó)際醫(yī)療中心干細(xì)胞治療怎么樣?
- 2024-11-16干細(xì)胞移植青光眼能治好嗎,效果如何
- 2024-11-04瑞士干細(xì)胞治療優(yōu)勢(shì)有哪些?
- 2024-09-26干細(xì)胞技術(shù)能治療哪些病,治療范圍廣泛
- 2024-09-02scm干細(xì)胞填充效果好嗎,scm臍帶血干細(xì)胞使用方法
- 2024-10-19張愛(ài)民干細(xì)胞療法的效果與評(píng)價(jià)如何?
- 2024-09-14西安干細(xì)胞注射價(jià)格表,西安哪里可以打干細(xì)胞
- 2024-07-23醫(yī)院干細(xì)胞存儲(chǔ),醫(yī)院干細(xì)胞存儲(chǔ)費(fèi)用多少
- 2024-08-06干細(xì)胞去眼袋有效果嗎,打細(xì)胞去眼袋多久能修復(fù)
- 2024-09-27廣州貝拉國(guó)際醫(yī)療中心怎么樣
- 2024-10-04安徽干細(xì)胞價(jià)格貴不貴,如何獲取準(zhǔn)確報(bào)價(jià)
- 2024-08-14干細(xì)胞治療眼睛疾病多少錢(qián)
- 2024-08-05干細(xì)胞治療類(lèi)風(fēng)濕,干細(xì)胞治療類(lèi)風(fēng)濕的效果如何
- 2024-09-14國(guó)家干細(xì)胞存儲(chǔ)公司有哪些,內(nèi)附公司名單
- 2024-09-07干細(xì)胞技術(shù)高度近視能恢復(fù)嗎,何時(shí)可以臨床
- 2024-10-11醫(yī)生如何看待干細(xì)胞療法?干細(xì)胞研究有哪些進(jìn)展?
- 2024-09-14西安干細(xì)胞注射價(jià)格表,西安哪里可以打干細(xì)胞
- 2024-10-04安徽干細(xì)胞價(jià)格貴不貴,如何獲取準(zhǔn)確報(bào)價(jià)
